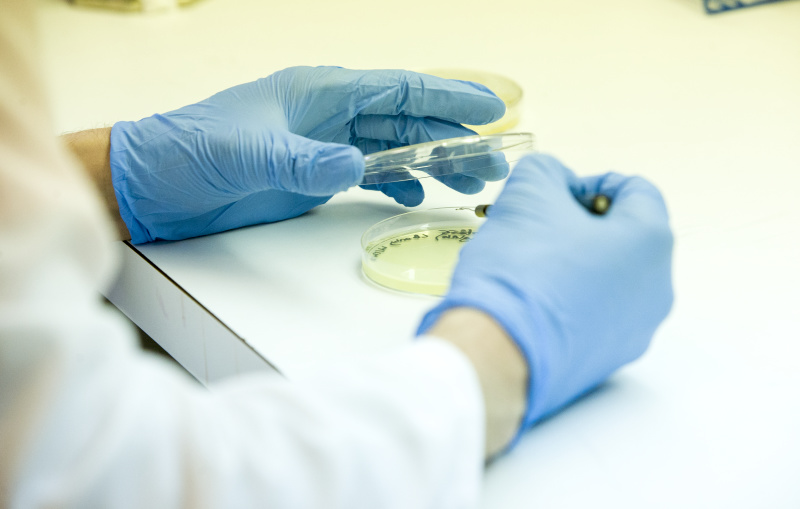
This is alt text for the image

Faculty Resources
Quick Links for University Research Compliance
Click here to go to the main University Research Compliance page.

Research Compliance Training
University Research Compliance (URC) facilitates training for the research community in order to promote compliance. All investigators and researcher personnel must complete mandatory training prior to beginning research at Oklahoma State University.
Responsible Conduct of Research (RCR) training Biosafety training Conflict of Interest (CoI) training Environmental Health and Safety (EHS) training IACUC training (for animal care and use) IRB training (for human subjects research) Laser safety training Radiation safety training
Human Subjects Research
Oklahoma State University is committed to and guided by the ethical principles regarding all research involving human subjects as set forth in the report of the National Commission for the Protection of Human Subjects of Biomedical and Behavioral Research entitled, "Ethical Principles and Guidelines for the Protection of Human Subjects of Research".
Institutional Review Board (IRB)
Animal Use
Oklahoma State University is committed to providing an animal care and use program that provides a humane and compliant environment for all animals involved in research, teaching, and testing activities.
Institutional Animal Care and Use Committee (IACUC)
Biosafety
Oklahoma State University is commited to utilzing national codes of practice and promoting health and safety in laboratories and the community.
Institutional Biosafety Committee (IBC)
Radiation Safety
The university's Radiation Safety Office is charged with the responsibility to ensure that all radioactive materials and machines capable of producing ionizing radiation are used in accordance with all applicable state and federal regulations.
Radiation Safety Office
Laser Safety
Oklahoma State University’s laser safety program adheres to appropriate ANSI standards with regard to Class 3B and Class 4 laser use on campus. The program is overseen by the Radiation Safety Office.
Laser Safety program
Conflict of Interest (CoI) - Disclosure Questionnaire
All administrators, faculty, staff, post-doctoral fellows and students who apply for, receive or serve as key personnel on a sponsored program must submit a disclosure questionnaire via the OneAegis for COI system before proposal submission at least annually during the period of award.
Conflict of Interest
Research Integrity
As an institution dedicated to excellence in education, research and outreach, Oklahoma State University places a high value on research integrity and academic freedom. Oklahoma State University takes concerns about research misconduct seriously.
Research misconduct